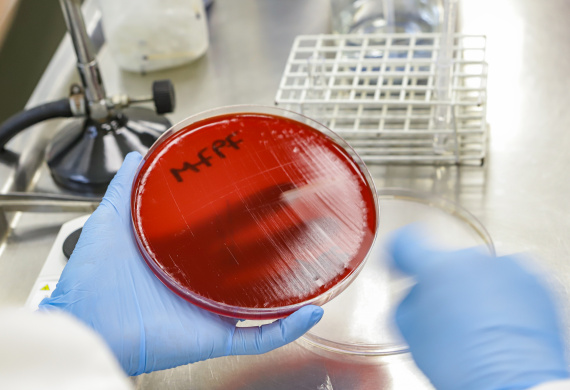
Lacen vira referência nacional e sai na vanguarda em projetos de monitoramento

Paraná, o Brasil que dá certo
Nesta série de reportagens da Agência Estadual de Notícias são mostradas iniciativas da administração pública estadual que são referência para o Brasil em suas áreas. O Paraná dispõe de profissionais de excelência e de programas de renome que dão ao estado a chancela de ser referência em diferentes áreas de atuação: na saúde, nas artes, na agricultura, na segurança e até na habitação. Com estas iniciativas, o Estado segue mudando vidas, dando oportunidades a quem mais precisa e facilitando a vida do cidadão, com serviços mais eficientes e pioneiros.